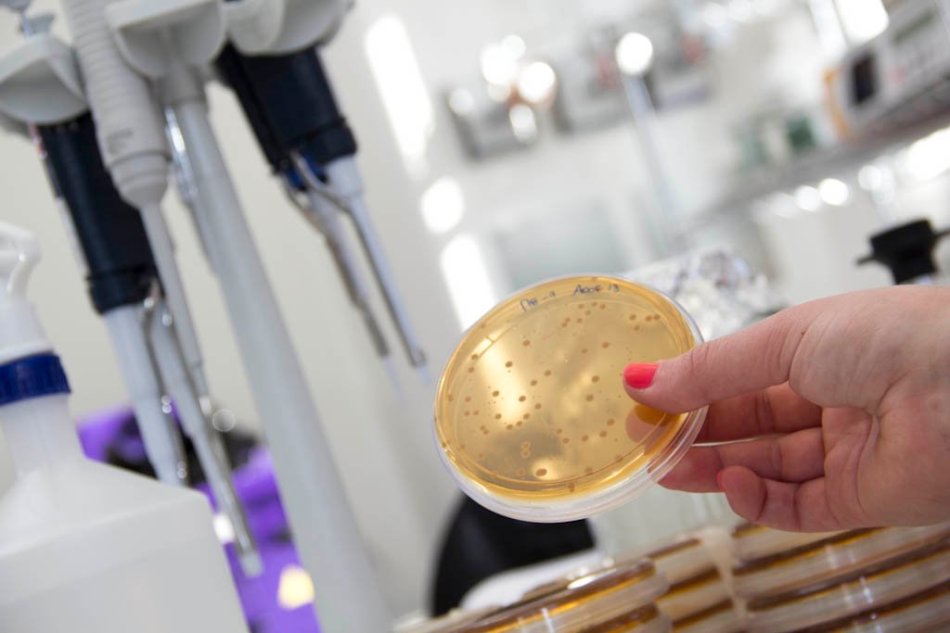

El ministro dio de baja cerca de mil servicios que prestaba el instituto a muy bajo costo. “No existen laboratorios privados en Argentina que puedan reemplazar esa función en el corto plazo”, advierten los trabajadores.
Por Werner Pertot.
La conducción mileista del INTI cumplió su amenaza de avanzar en el desguace total de la entidad y publicó un decreto en el que dio de baja cerca de mil servicios que prestaban a empresas privadas en materia de control de alimentos, bebidas, materiales de construcción y una larga lista de controles críticos. Como publicó este diario, la medida implica un mayor riesgo para la población. El ministro de Desregulación y Desorden de la Vida, Federico Sturzenegger, festejó la medida con el insólito argumento de que el INTI “ofrecía estos servicios a un precio muy bajo” y por eso había que eliminarlos. Desde trabajadores del INTI hasta diputados opositores le llenaron la cara de verdades, le corrigieron una extensa serie de errores groseros -o faltas absolutas a la verdad- que incluyó en su tuit.
La medida se venía anunciando, pese a que la conducción del INTI recibió una nota firmada por los subgerentes operativos que planteaba serios riesgos al avanzar por esa vía, además de que pone en riesgo 700 puestos de trabajo. Entre los principales riesgos, los subgerentes del INTI indicaron que no hay una oferta suficiente en el ámbito privado para reemplazar los controles, que algunos de ellos afectan exportaciones y estándares internacionales y que otros tienen que ver con el desarrollo de nuevas tecnologías. Además advierten sobre la irreversibilidad de la medida que implica la “pérdida del conocimiento técnico acumulado (know-how), desarticulación de equipos especializados y dificultad de reconstruccion de las capacidades en el mediano o largo plazo, con impacto directo en la infraestructura pública en relación a la calidad e innovación”.
Por supuesto, nada de esto importó y salió la resolución 42/26 que desarticuló todo, firmada por el presidente del INTI Miguel Ángel Romero, Ezequiel Capelli y Juan Pablo Intelisano. Y atrás, se subió Sturzegger a festejar, con los siguientes argumentos:
*“Muchos de ellos se utilizaban muy poco”, aseguró. Aunque este diario informó que la gestión libertariana prohibió viáticos, incumplió contratos con empresas y subió aranceles para desarticular la demanda en los últimos dos años.

*“El problema era que el INTI ofrecía estos servicios a un precio muy bajo, lo cual quiere decir que era el contribuyente (como decimos comúnmente “el IVA a la polenta”) el que financiaba estos servicios. En otras palabras, el servicio era un subsidio a ciertas empresas financiados por todos nosotros».
*“El caso más escandaloso (que sirve para ilustrar el punto) es el servicio de control de expendio de los surtidores de combustibles que las petroleras están obligadas a hacer periódicamente. Aproximadamente un 12% de la planta del INTI hacía ese test”.
Desde la Multisectorial de Trabajadores del INTI pasaron a desasnar al ministro en algunos errores serios que cometió en su posteo. Advierten que no es el 12 por ciento del plantel del INTI el que verifican surtidores: “Evidentemente no leyó bien el machete que le pasaron, porque sí son 12, ¡pero son la cantidad de camionetas que realizaban las verificaciones y que involucraba a 24 de los 2300 trabajadorxs que somos en la actualidad!“, contestaron. Es decir que en lugar de ser el 12 por ciento, eran más cerca del uno por ciento y no el 12. Un error comprensible para Stuzenegger, que no tiene formación en matemáticas ni ciencias exactas.
Entre otras contadas de costillas del documento que publicaron los trabajadores, está:
- “Sturzenegger comienza diciendo que se bajan servicios que “no tenían ninguna especificidad” y da como ejemplo un ensayo específico como el que se requiere para conocer la durabilidad de un producto”. Quod erat demostrandum, pero al revés.
- “Acusa al INTI por dar servicios a precios muy bajos (como debe hacer un organismo que no busca la ganancia sino el desarrollo de un sector) y ahí rebuzna mintiendo una vez más y declama que esos servicios los paga el contribuyente. Pues no, los servicios los paga los empresarios que los requieren, por eso tienen un precio Federico, sino serían gratis”.
A continuación de los trabajadores del INTI, se sumó a la fila de desasnar a Sturzennegger la diputada y economista Julia Strada, quien lejos de considerarlo una persona iletrada o con malos cálculos le enrostró en mayúsculas un “STURZENEGGER ESTAS MINTIENDO”.

“Hay un problema de base que es desconocer (o pretender desconocer) el rol que cumplen estas herramientas en cualquier estrategia de desarrollo productivo. No se trata de servicios “de mercado” en sentido estricto, sino de infraestructura tecnológica que permite que el entramado productivo -y en particular las PyMEs- acceda a capacidades técnicas a costos razonables”, argumentó.
“Decís que los servicios del INTI “no tenían ninguna especificidad particular”. ¿EN SERIO? Basta con mirar ejemplos concretos. 1. El INTI capacita a empresas alimenticias en procesos críticos como el envasado al vacío -una tecnología clave para la conservación y la calidad-. 2. Otro ejemplo concreto: se eliminó un ensayo dentro de una batería de pruebas destinadas al control de bolsones utilizados para el transporte de sustancias peligrosas, como el litio. Ese ensayo fue dado de baja siendo el INTI el único laboratorio en el país con capacidad técnica para realizarlo», advirtió la diputada, quien destacó que “estos ensayos son requeridos por Prefectura y Gendarmería para habilitar el traslado de litio como sustancia peligrosa”.
Mientras Sturzenegger citaba películas y fantaseaba con empresarios que lloraron de alegría con el desguace del INTI, Strada le planteó concretamente que “no existen laboratorios privados en Argentina que puedan reemplazar esa función en el corto plazo. De hecho, empresas de Paraguay consultaban al INTI para realizar estos ensayos ante la falta de capacidades en la región”.
Strada le refutó también el craso error sobre los surtidores, que contenía más impresiciones como que no se usan “receptáculos” sino “medidas patrón de volumen con trazabilidad internacional, calibradas contra los patrones nacionales”. Y le advierte que es una actividad regulada desde 1932, “que se aplica de manera equivalente en países como Estados Unidos”. “Es grave que seas tan burro”, le espeta.
Y siguió dando ejemplos puntuales, alejados del festejo del ministro desregulador: “Voy a enumerar para que se entienda: el INTI controla que las pinturas no contengan plomo, realiza ensayos de seguridad en autopartes y materiales de la construcción, desarrolla alimentos sin TACC, verifica que los juguetes que usan los niños/as no tengan materiales tóxicos como los ftalatos, calibra las balanzas utilizadas en el comercio exterior para que el tonelaje de granos sea efectivamente el declarado y tiene un rol clave en la salud, por ejemplo en la calibración de analizadores que permiten verificar el funcionamiento de equipos como los desfibriladores“.
Todo eso ahora queda a la suerte de que los privados controlen a los privados, es decir, se controlen a sí mismos, como festejó Sturzenegger. Porque el mercado se regula solo. ¿O no?
Fuente: Página 12

0 comments on “ARGENTINA. La vida no vale nada: Sturzenegger elimina controles y pone en riesgo la salud de los argentinos”